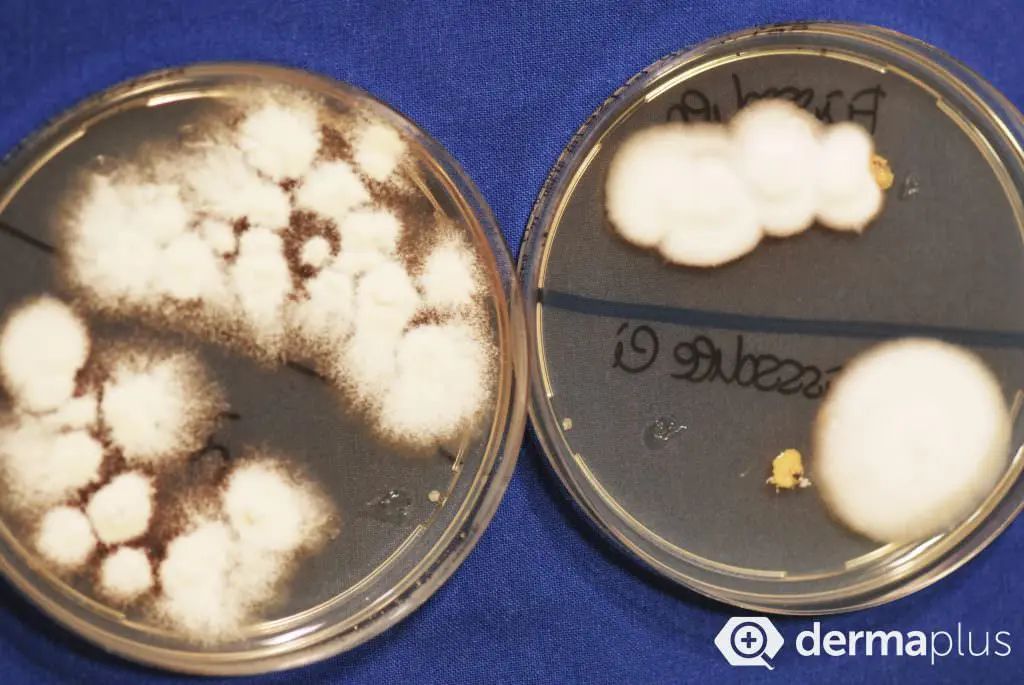

Winkelwagen
U heeft geen artikelen in uw winkelwagen
Ösophagus:
Eine Candida-Infektion der Speiseröhre kann durch Inhalation von Medikamenten (Kortikosteroide bei Asthma), Intubation während einer Operation und Rauchen verursacht werden.
Vagina:
Neben den allgemeinen Ursachen können Hormonschwankungen während der Schwangerschaft und durch die Pille zu einer Candida-Infektion führen. Auch ein durch Seife gestörter Säurehaushalt kann Candida verursachen.
Penis:
Candida-Infektionen am Penis sind nicht häufig, können aber durch eine enge Vorhaut oder durch eine Candida- Übertragung von einer Partnerin/einem Partner verursacht werden, denn obwohl Candida ist keine STD (Geschlechtskrankheit) ist, kann sie übertragen werden.
Mundwinkel:
Neben den allgemeinen Ursachen von Candida kann Candida auch durch Risse in den Mundwinkeln, schlecht sitzende oder herausstehende Zahnprothesen verursacht werden.
Generalisierte Candida-Infektion:
In seltenen Fällen gelangt Candida ins Blut. Diese Form tritt bei Menschen mit einem stark geschwächten Immunsystem auf.
Hierzu gehören Haut- oder Schleimhautveränderungen, welche dem Pilz das Eindringen in den Körper erleichtern. Beispielsweise
Eine geschwächte Immunabwehr begünstigt die Verbreitung des Pilzes. Eine Immunschwäche kann angeboren sein, aber auch erst im Laufe des Lebens auftreten, zum Beispiel als Folge von
Alte Menschen und sehr kleine Säuglinge beziehungsweise Frühgeborene verfügen ebenfalls oft nur über verminderte Abwehrkräfte. Eine Behandlung mit Antibiotika kann die normale Haut- und Darmflora verändern und so dem Pilz ein vermehrtes Wachstum ermöglichen.

| Testverfahren | Sensitivität |
|---|---|
| Mikroskopie eines Nativpräparates mit Kalilauge | 70-80% |
| Kulturelle Errergeranzüchtung | 50-60% |
| Histopathologischer Nachweis | 80% |
Differentialdiagnostische Probleme können immer wieder auftreten. Zu den wichtigsten Krankheiten, die diagnostisch mit dem Nagelpilz verwechselt werden, gehören Ekzemnägel, Druck-bedingte Verletzungen am Nagel, irritativ-toxisch bedingte Schädigungen der Nägel (zum Beispiel durch Formaldehyd-haltige Onychomykose Nagellacke), genetisch-bedingte Nagel Erkrankungen sowie eine die Nägel betreffende Schuppenflechte (Psoriasis). In unserem Journalbeitrag finden Sie weitere Informationen zu den Zusammenhängen zwischen Nagelpsoriasis und Nagelpilz.
Abb. 5: Nagelpsoriasis: Im Gegensatz zur Onychomykose zeigt sich bei der die Nägel befallenden Schuppenflechte mehrheitlich ein Befall aller Nägel.
Abb. 6: Druck-bedingte Nagelschädigung: Traumatische Nagelschädigung mit Nageleinblutung aufgrund zu enger Skischuhe